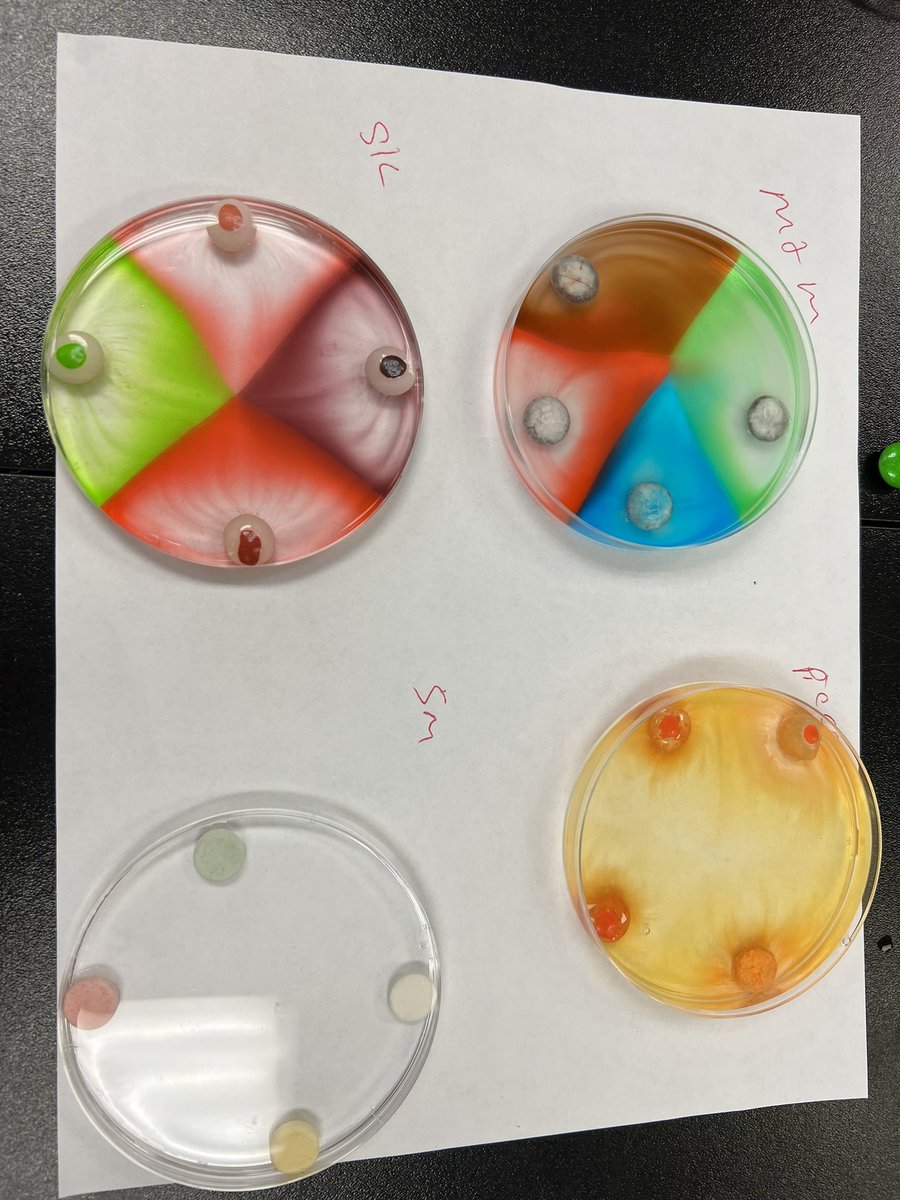
MsDeBottisbio's tweet image. What else would I be doing during my first week of summer vacation??? PD of course! #ExplorebeforeExplain I love learning new strategies with minimal prep time, but maximum output for my students! @HumbleISD_PL @Humble_2ndSci  New ideas are flowing already! 🧠 @HumbleISD_KPHS

#explorebeforeexplain wyniki wyszukiwania
Advanced Bio Ss exploring diffusion. #explorebeforeexplain #ALLstudentsAREscienrists @HumbleISD_AHS @Humble_2ndSci @HumbleISD_ADV @DrSashaBlake @mslagleAHS @ElissaGriffin3




Real science starts with exploration! Our "Explore-Before-Explain" lesson turns students into light and shadow investigators. They collect data & build their own concepts tandfonline.com/doi/full/10.10… #NSTA #ExploreBeforeExplain
💡 Is it skill or will? Our Science Cadre explored Crucial Influence, growing their impact through student-centered planning while embracing Explore Before Explain and Develop & Use Models. 🌎✨ Science isn’t just taught — it’s experienced. #DoingScience #explorebeforeexplain




Students explored Newton’s First Law today and used the inquiry matrix to generate questions before taking notes. Great job doing science! #ExploreBeforeExplain #DoingScienceDaily #RowTheBoat @GwenanneGabel @DLandry310 @HumbleISD_WMS


Learning about #explorebeforeexplain in this Mon morning! Already adding things to our learning set and eager to apply what we’ve done this morning! #dob4no #YourTurn2Learn


Secondary Science teachers #ExploreBeforeExplain building paper towers! @MrsJackSciHacks @serna_rosalinda #DoingScienceDaily


We are starting our force unit in 6th grade science with #ExploreBeforeExplain.. 🧐 The kids did an awesome job collaborating and discussing their observations and reflections this morning! #KMSCougarPride




🪨💡 Our Science Cadre ROCKED collaboration today, literally! Teams explored before explaining to model how sedimentary rocks and fossil fuels form @ Jesse Jones Park! Layer by layer, curiosity built up under pressure! 🔬🔥 #DoingScience #ExploreBeforeExplain




@HumbleISD_WMS 8th Science student were #DoingScience by exploring how hydrophobic sand can show us some properties of water! They had an absolute blast experimenting today! #BeElite #ExploreBeforeExplain @Humble_2ndSci


“I notice, I wonder, I think” had 7th grade scientists exploring changes to matter while using prior knowledge and evidence to justify their ideas for whether changes were physical or chemical #EXPLOREbeforeExplain #ALLstudentsAREscientists @Humble_2ndSci @HumbleISD_TMS




What else would I be doing during my first week of summer vacation??? PD of course! #ExplorebeforeExplain I love learning new strategies with minimal prep time, but maximum output for my students! @HumbleISD_PL @Humble_2ndSci New ideas are flowing already! 🧠 @HumbleISD_KPHS

Today was AWESOME being around pioneers of @HumbleISD ! We explored in @PrismsOfReality with @Humble_2ndSci !! So excited our students get to be world problem solvers in VR this year! #explorebeforeexplain #ALLstudentsAREscientists @HumbleISD_PL

Modeling antibiotic resistance with Ts in Montgomery County, PA. A great way to start your students talking about evolution on day one! #ngss #explorebeforeexplain #phenomena



“Explore BEFORE explain for curiosity’s sake” @Humble_2ndSci @HumbleISD_PL @serna_rosalinda #explorebeforeexplain #ifTHEYbuildittheywillLEARN #thinkFIRST




@SBISDScience have an amazing time learning about #3D learning! #explorebeforeexplain #phenomena #inquiry


Does ice have the same mass once it melts into water? @NISDElemScience #TeamSciSS #ExploreBeforeExplain

🌳🦎 Our Cadre closed out the day @JesseJonesPark with some cool creatures — a turtle, a leaf bug, and a blue-tongued skink! 🐢🪲 Exploring structure & function and adaptations that help them survive and thrive. Thanks for having us! #doingscience #explorebeforeexplain




What if your confusion isn’t a lack of clarity, but a sign that you’re outgrowing the framework you were taught to think within? Let the not-knowing stretch you. Let it undo the limits. Some answers can only be felt, not found.

Inhabit the space before narratives come in to make sense of what's going on
Sometimes, the path isn't clear, and one must choose between following directions and forging ahead into the unknown. It is important to trust your instincts, even when they contradict the map. #gaming #exploration
You do not need to wait for permission from the world to explore what you're genuinely curious about. 🤍

Travel isn’t about checking places off a list, it’s about discovering parts of yourself you didn’t know existed.


Before you act_ask why. Before you chase_ask where does it lead.
In terms of what I call explore ‘em ups, this is the best. DO NOT look up guides or spoilers unless you’re really really stuck, just get out into the universe and find stuff on your own, and connect the dots. I ENVY you doing this for the first time
Try looking at the world around you and describe it without using words. You'll quickly find you're tapping into a peculiar field worth discovering further in silence. youtube.com/watch?v=iDGMS_…

youtube.com
YouTube
Waking Life _ Words Are Inert
showing things before telling is often a good strategy. Let people notice, wonder, ask questions.
People tune me out when I mention explicit instruction. But when I show them a video of my instruction, they always say "Oh! It looks so interactive! I thought you were just lecturing." So I'm thinking...maybe we need to show them first and then tell them. @MrZachG
This is what people should be doing, exploring instead of hiding behind their keyboards and becoming sub-humans 🫠




Always venture deeper.. Explore..Learn and Unlearn! The cave you fear to enter holds all the answers!

Do you find yourself more intrigued when what’s really there is a little obscure or hidden? 😊

Exploring the unknown is where the magic happens. Step outside your comfort zone and #Explore new perspectives. You never know what hidden wonders you might uncover.
There’s a kind of travel that doesn’t shout — it whispers. page.fo/karen-travel Expedition cruising isn’t about ticking boxes or chasing sunsets. It’s about rediscovering wonder. 🌍 #BeyondTheTouristTrail #ExpeditionCruising #MeaningfulTravel #TravelTh...

Even if you don’t know where you’re going that in itself should be appreciated Not knowing is part of the adventure Enjoy

obviously it gets more complicated, there's the whole "explore vs exploit" layer i.e. what if you don't know what your options are? you have to find out what your options are you also have to figure out how much joy your options give you and how much pain they erase
Harness that creativity with the Explore-Before-Explain model. Let them investigate and build evidence (like designing paper helicopters!) before diving into the formal explanation. It builds confidence and innovative thinking. #NSTA #STEM #SciEd tandfonline.com/doi/full/10.10…
Advanced Bio Ss exploring diffusion. #explorebeforeexplain #ALLstudentsAREscienrists @HumbleISD_AHS @Humble_2ndSci @HumbleISD_ADV @DrSashaBlake @mslagleAHS @ElissaGriffin3




OTHS science dept engaging in a 5E lesson this morning. Ready to continue the inquiry journey!#explorebeforeexplain




Learning about #explorebeforeexplain in this Mon morning! Already adding things to our learning set and eager to apply what we’ve done this morning! #dob4no #YourTurn2Learn


Secondary Science teachers #ExploreBeforeExplain building paper towers! @MrsJackSciHacks @serna_rosalinda #DoingScienceDaily


Light Exploration Stations! #exploreBEFOREexplain #Science #TECH #funin4th @oceeotters @AnnScottHanks10 @FultonCoSchools




Science at @WesternHillsES! Exploring circuits and electricity! #ExplorebeforeExplain @CarminiaGonz @MrsTrotterSci @StaceyLeonardB1 @mrshilbs11 @shanny6494




Students explored Newton’s First Law today and used the inquiry matrix to generate questions before taking notes. Great job doing science! #ExploreBeforeExplain #DoingScienceDaily #RowTheBoat @GwenanneGabel @DLandry310 @HumbleISD_WMS


After formulating questions about what they wonder and want to learn about magnets, these scientists got to explore!! #explorebeforeexplain @oceeotters @AnnScottHanks10

Exploration time with random objects before learning all about the rules of measurement! #explorebeforeexplain @oceeotters


How does light behave when interacting with different materials? #Science #funin4th #exploreBEFOREexplain @oceeotters @AnnScottHanks10


“Explore BEFORE explain for curiosity’s sake” @Humble_2ndSci @HumbleISD_PL @serna_rosalinda #explorebeforeexplain #ifTHEYbuildittheywillLEARN #thinkFIRST




Level Chemistry students @HumbleISD_KHS are exploring atomic structure to determine identify. #ExploreBeforeExplain #ALLstudentsAREscientists #KingwoodALLIN


Our CSSs and Science teachers were ALL IN at our Grade 5 Science Collaboratory today. Thank you for your hospitality @holmeselem, we loved spending the day at your bright & beautiful campus. #DontKillTheWonder #ExploreBeforeExplain @MDCPSDAS @trydiggs @docdn83 @YeseniaAponte05



Adv. Biology @HumbleISD_KHS students are exploring what enzymes do in order to explain how and why they work. #ExploreBeforeExplain #ALLstudentsAREscientists #KingwoodALLIN


Primary source scavenger hunt! What do you notice? What do you wonder? What questions do you have? What connections can you build between the documents and your prior knowledge? #explorebeforeexplain #primarysources channeling my inner @AnnScottHanks10

Today we investigated animal coverings! Students wrote down describing words and made predictions about where these different materials came from. I love hearing their rationalizations for each station! @oceeotters #explorebeforeexplain #realscience



What conclusions can we draw about plants if we try to sort them? Do some fit into multiple categories? Why are some of them shaped differently? #explorebeforeexplain #learningshouldbefun




Something went wrong.
Something went wrong.
United States Trends
- 1. Thanksgiving 2.04M posts
- 2. Chiefs 71.2K posts
- 3. Chiefs 71.2K posts
- 4. Mahomes 24K posts
- 5. George Pickens 10.3K posts
- 6. McDuffie 5,617 posts
- 7. Post Malone 4,599 posts
- 8. Tony Romo 2,544 posts
- 9. Sarah Beckstrom 90.5K posts
- 10. #KCvsDAL 7,013 posts
- 11. Turpin 1,687 posts
- 12. Lions 98.2K posts
- 13. Packers 73.3K posts
- 14. Spags 1,559 posts
- 15. Rashee Rice 3,595 posts
- 16. Dak Prescott 5,031 posts
- 17. Kelce 13.7K posts
- 18. Andy Reid 1,602 posts
- 19. Hollywood Brown N/A
- 20. Clowney N/A



























































